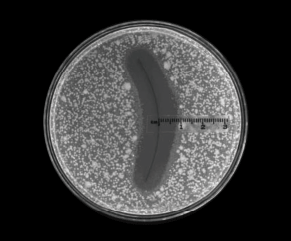

医療従事者の確認
当サイトは医療従事者の方々および、ジョンソン・エンド・ジョンソン株式会社の製品をお使いの方々に対し、これらの製品を適正にご使用頂くことを目的としています。一般のお客様への情報提供を目的としたものではありませんので、ご了承ください。
あなたは医療従事者ですか?
PDS®Ⅱの長期抗張力保持期間はそのままに、6種類(黄色ブドウ球菌・表皮ブドウ球菌・メチシリン耐性黄色ブドウ球菌・メチシリン耐性表皮ブドウ球菌・大腸菌・肺炎桿菌)の細菌の縫合糸上におけるコロニー形成を抑制する抗菌作用を持つモノフィラメント抗菌縫合糸です。
![]()

![]()
Xintian Ming, et al. In Vivo and in Vitro antibacterial efficacy of PDS Plus Suture, Surgical Infections Vol. 9, No.4, 2008 451-457
イメージ図。抗菌阻止帯試験の結果は状況により変化する可能性があります。
高度管理医療機器 販売名:PDS プラス 承認番号:22300BZX00333000
ログアウトします。よろしいですか?
※空白で区切られた複数の単語の検索が可能です。
※二重引用符を追加することで一つの単語として検索することも可能です。
(例:"XXXX 病院")